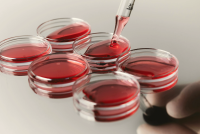
From-Fragmentation-to-Unification_-How-Life-Sciences-Is-Becoming-a-Connected-Ecosystem.png

全球风能理事会发布了“2025年全球海上风电报告”。海上风电的征程始于1991年丹麦在洛兰岛附近安装的首批海上风力涡轮机。自那时起,它已演变成一个显著增长的故事。如今,这项技术在全球范围内提供大规模、成本效益高的清洁电力——为企业注入活力、提振经济并振兴沿海地区。随着全球装机容量达到83吉瓦,海上风电目前为7300万户家庭供应清洁、可负担的电力。
GWEC:2025年全球海上风电报告
No posts found matching your query. Please try again by changing post parameters.